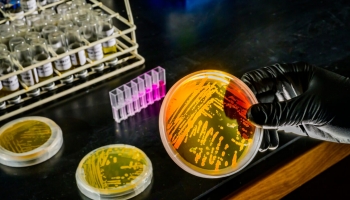
thumbimg

세계
- 호르무즈 해협 봉쇄 장기화?...'기뢰'가 국제유가 새 변수로 등장
- 2026-03-13 [조인준]
- 호주, 석탄광산 채굴 2038년까지 연장…1.5℃ 기후목표 '흔들'
- 2026-03-13 [김혜지]
- 온난화로 심해까지 '뜨끈'...미생물은 오히려 활발해진다?
- 2026-03-12 [김나윤]
- 빈곤·교육 격차가 클수록 환경파괴 심해진다
- 2026-03-12 [김혜지]
- 캐나다 제설된 눈더미 '골머리'...소금과 유독물질 '하천 유입'
- 2026-03-12 [김나윤]
- 기후변화에 전쟁까지 '겹악재'...이란 '물부족' 사태 더 심해져
- 2026-03-11 [최대성]
- 북극해빙 녹으면 구름 줄어든다..."기후까지 영향"
- 2026-03-11 [김나윤]
- 바다에 화학물질 6만L 투입…'해양 알칼리화' 기술 '시험대'
- 2026-03-11 [김혜지]
- 전세계 인구 33% '극한폭염' 영향권..."일상활동 가능시간 줄고있어"
- 2026-03-11 [김나윤]
- [영상] 시속 265km 바람에 '초토화'...美중부 '괴물 토네이도' 연쇄 발생
- 2026-03-11 [김혜지]
- 50m 거대 쓰레기산 '와르르'…인니, 매립지 붕괴로 5명 매몰
- 2026-03-10 [김혜지]
- 멸종된 줄 알았던 英 '나비'…자연에서 수십년만에 모습 드러내
- 2026-03-10 [김혜지]